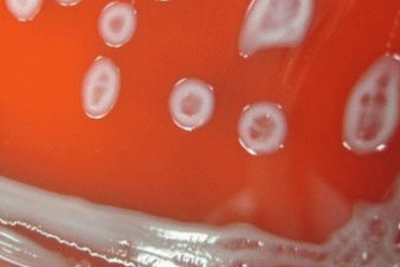
Lecleria adecarboxylata, an emerging pathogen

Ryan Cox, BS
Microbial Identification
Microbial Identification

Ryan joined Charles River in 2019. He currently works with Accugenix's Microbial Databases and Technology Transfer team as an associate scientist. He assists in the ongoing curation and maintenance of the MALDI-TOF Library, developing strain typing assays and other various projects to help improve the workflow of the laboratories. Ryan has a Bachelor of Science degree in chemistry from the University of Delaware.